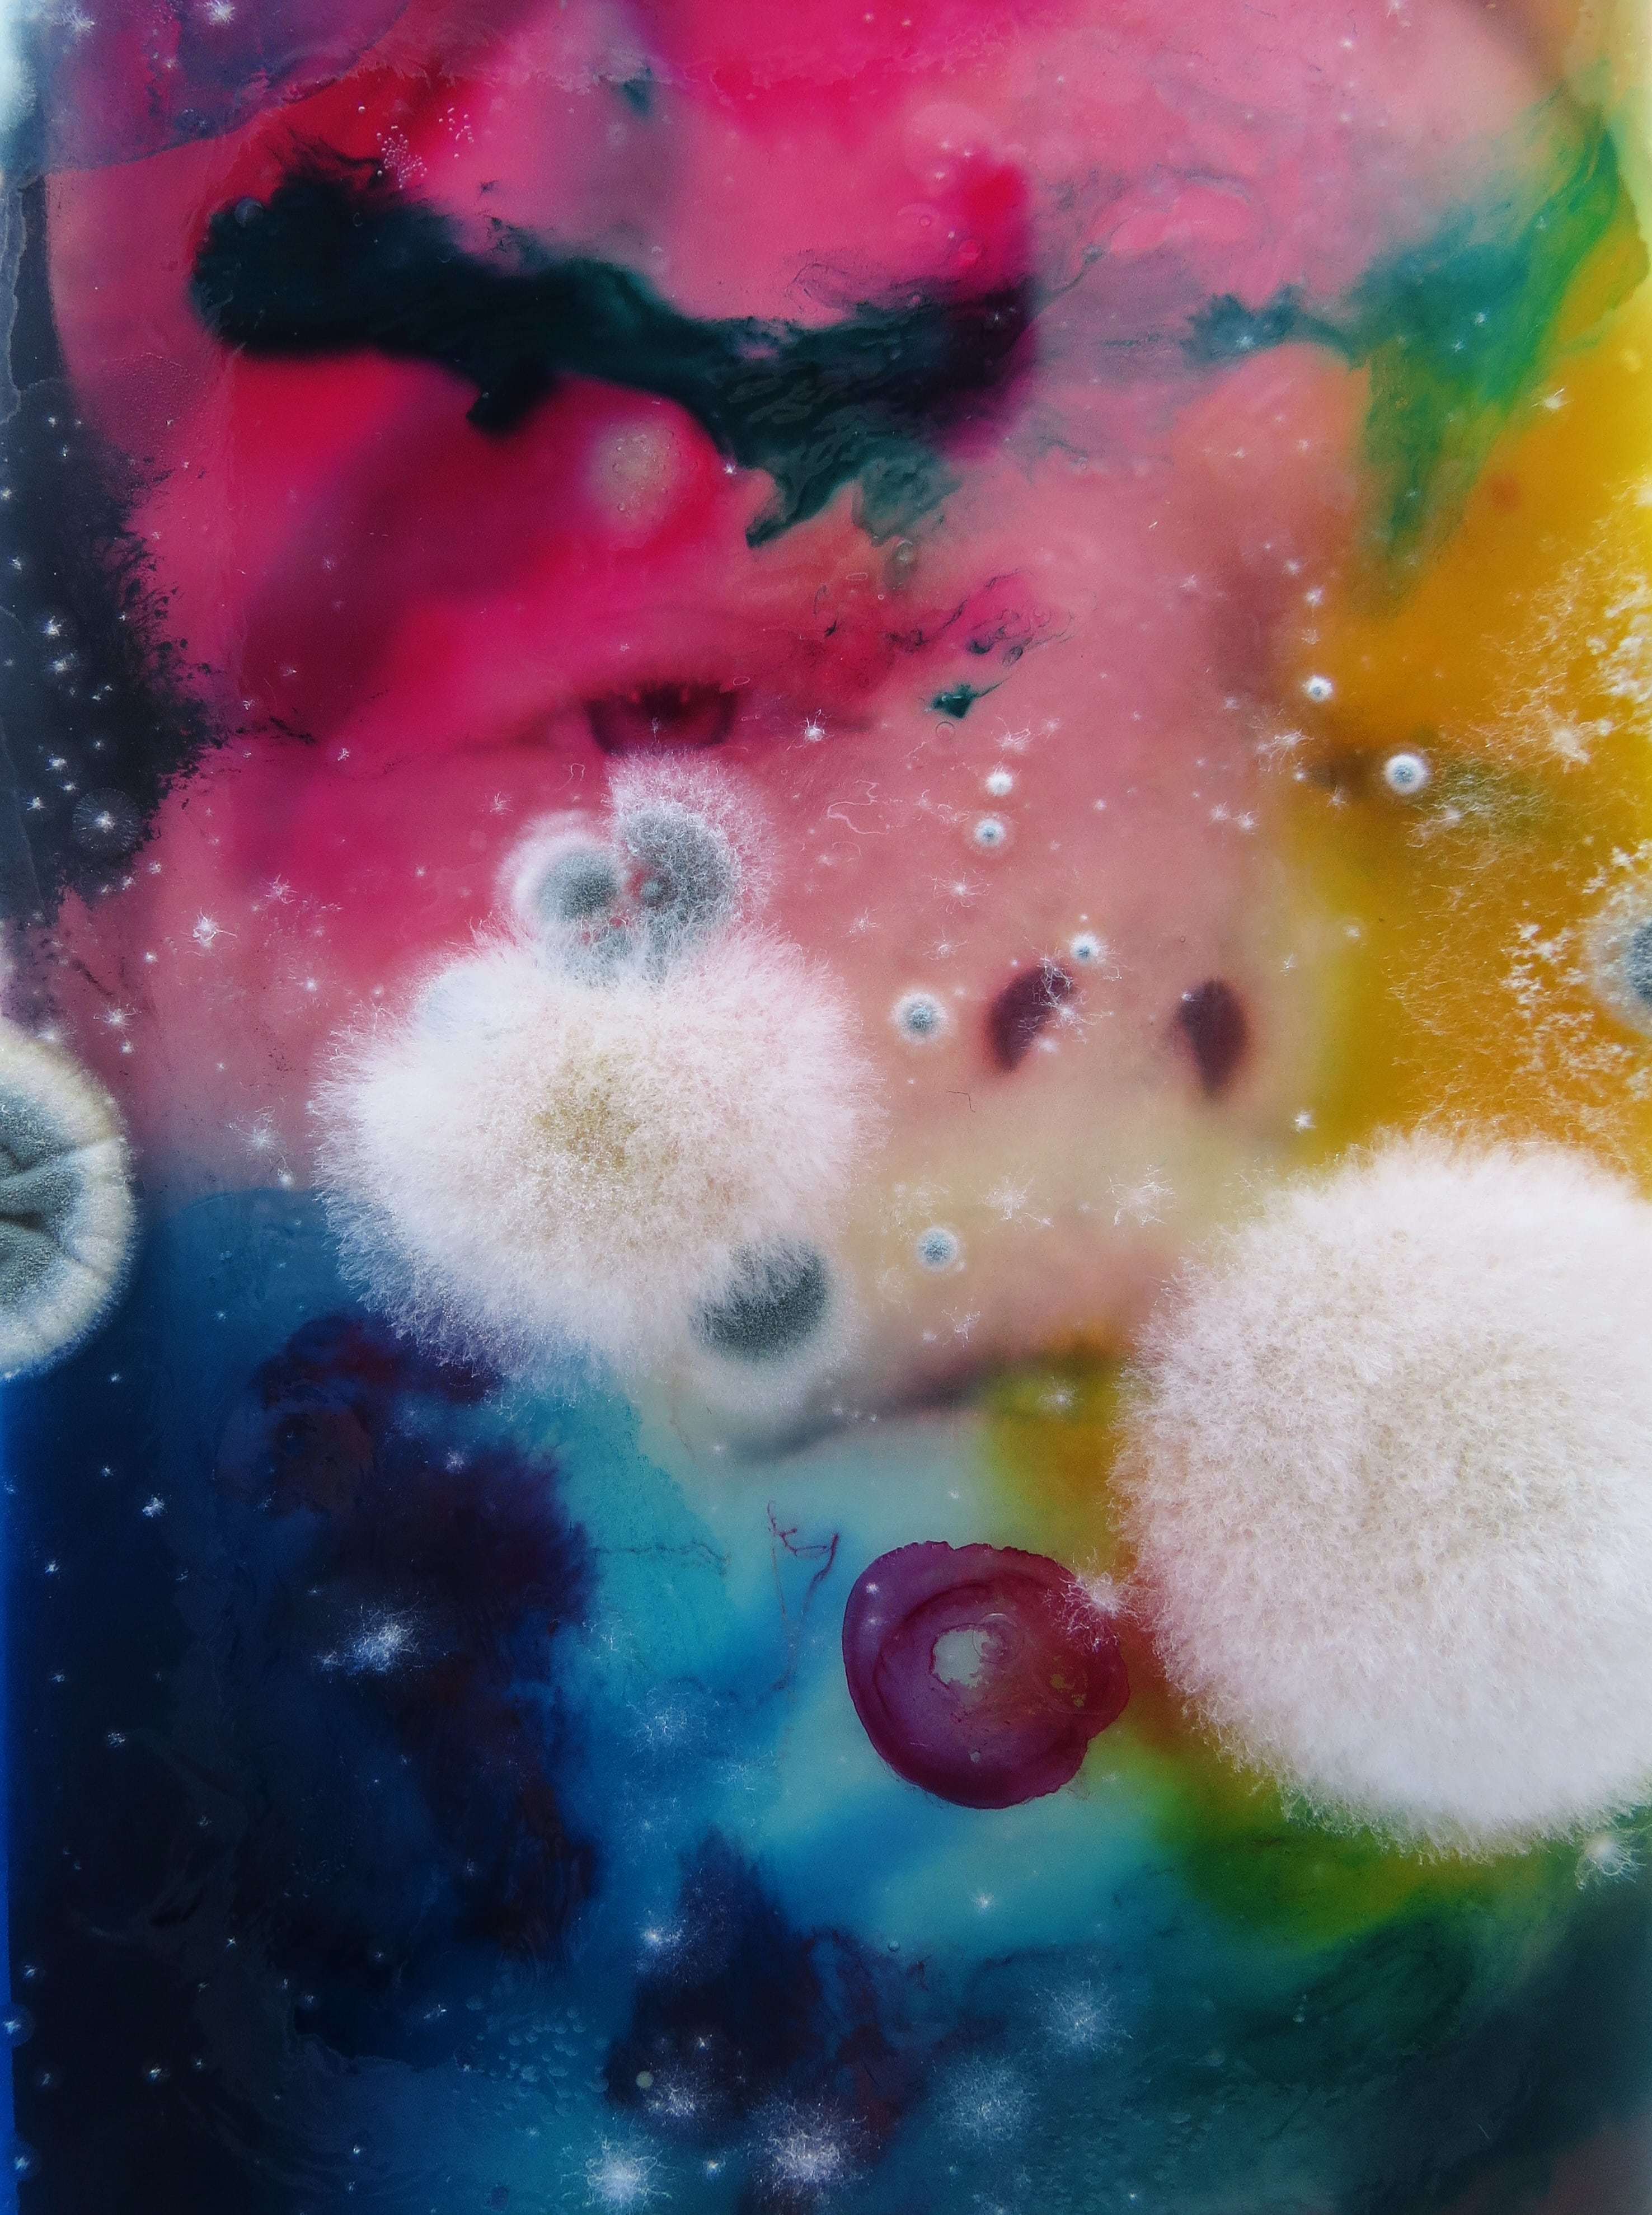
полезная плесень миф или правда. 0aa1b185b79fffa47db43c241d39e9fb. полезная плесень миф или правда фото. полезная плесень миф или правда-0aa1b185b79fffa47db43c241d39e9fb. картинка полезная плесень миф или правда. картинка 0aa1b185b79fffa47db43c241d39e9fb. полезная плесень миф или правда. 0aa1b185b79fffa47db43c241d39e9fb. полезная плесень миф или правда фото. полезная плесень миф или правда-0aa1b185b79fffa47db43c241d39e9fb. картинка полезная плесень миф или правда. картинка 0aa1b185b79fffa47db43c241d39e9fb.
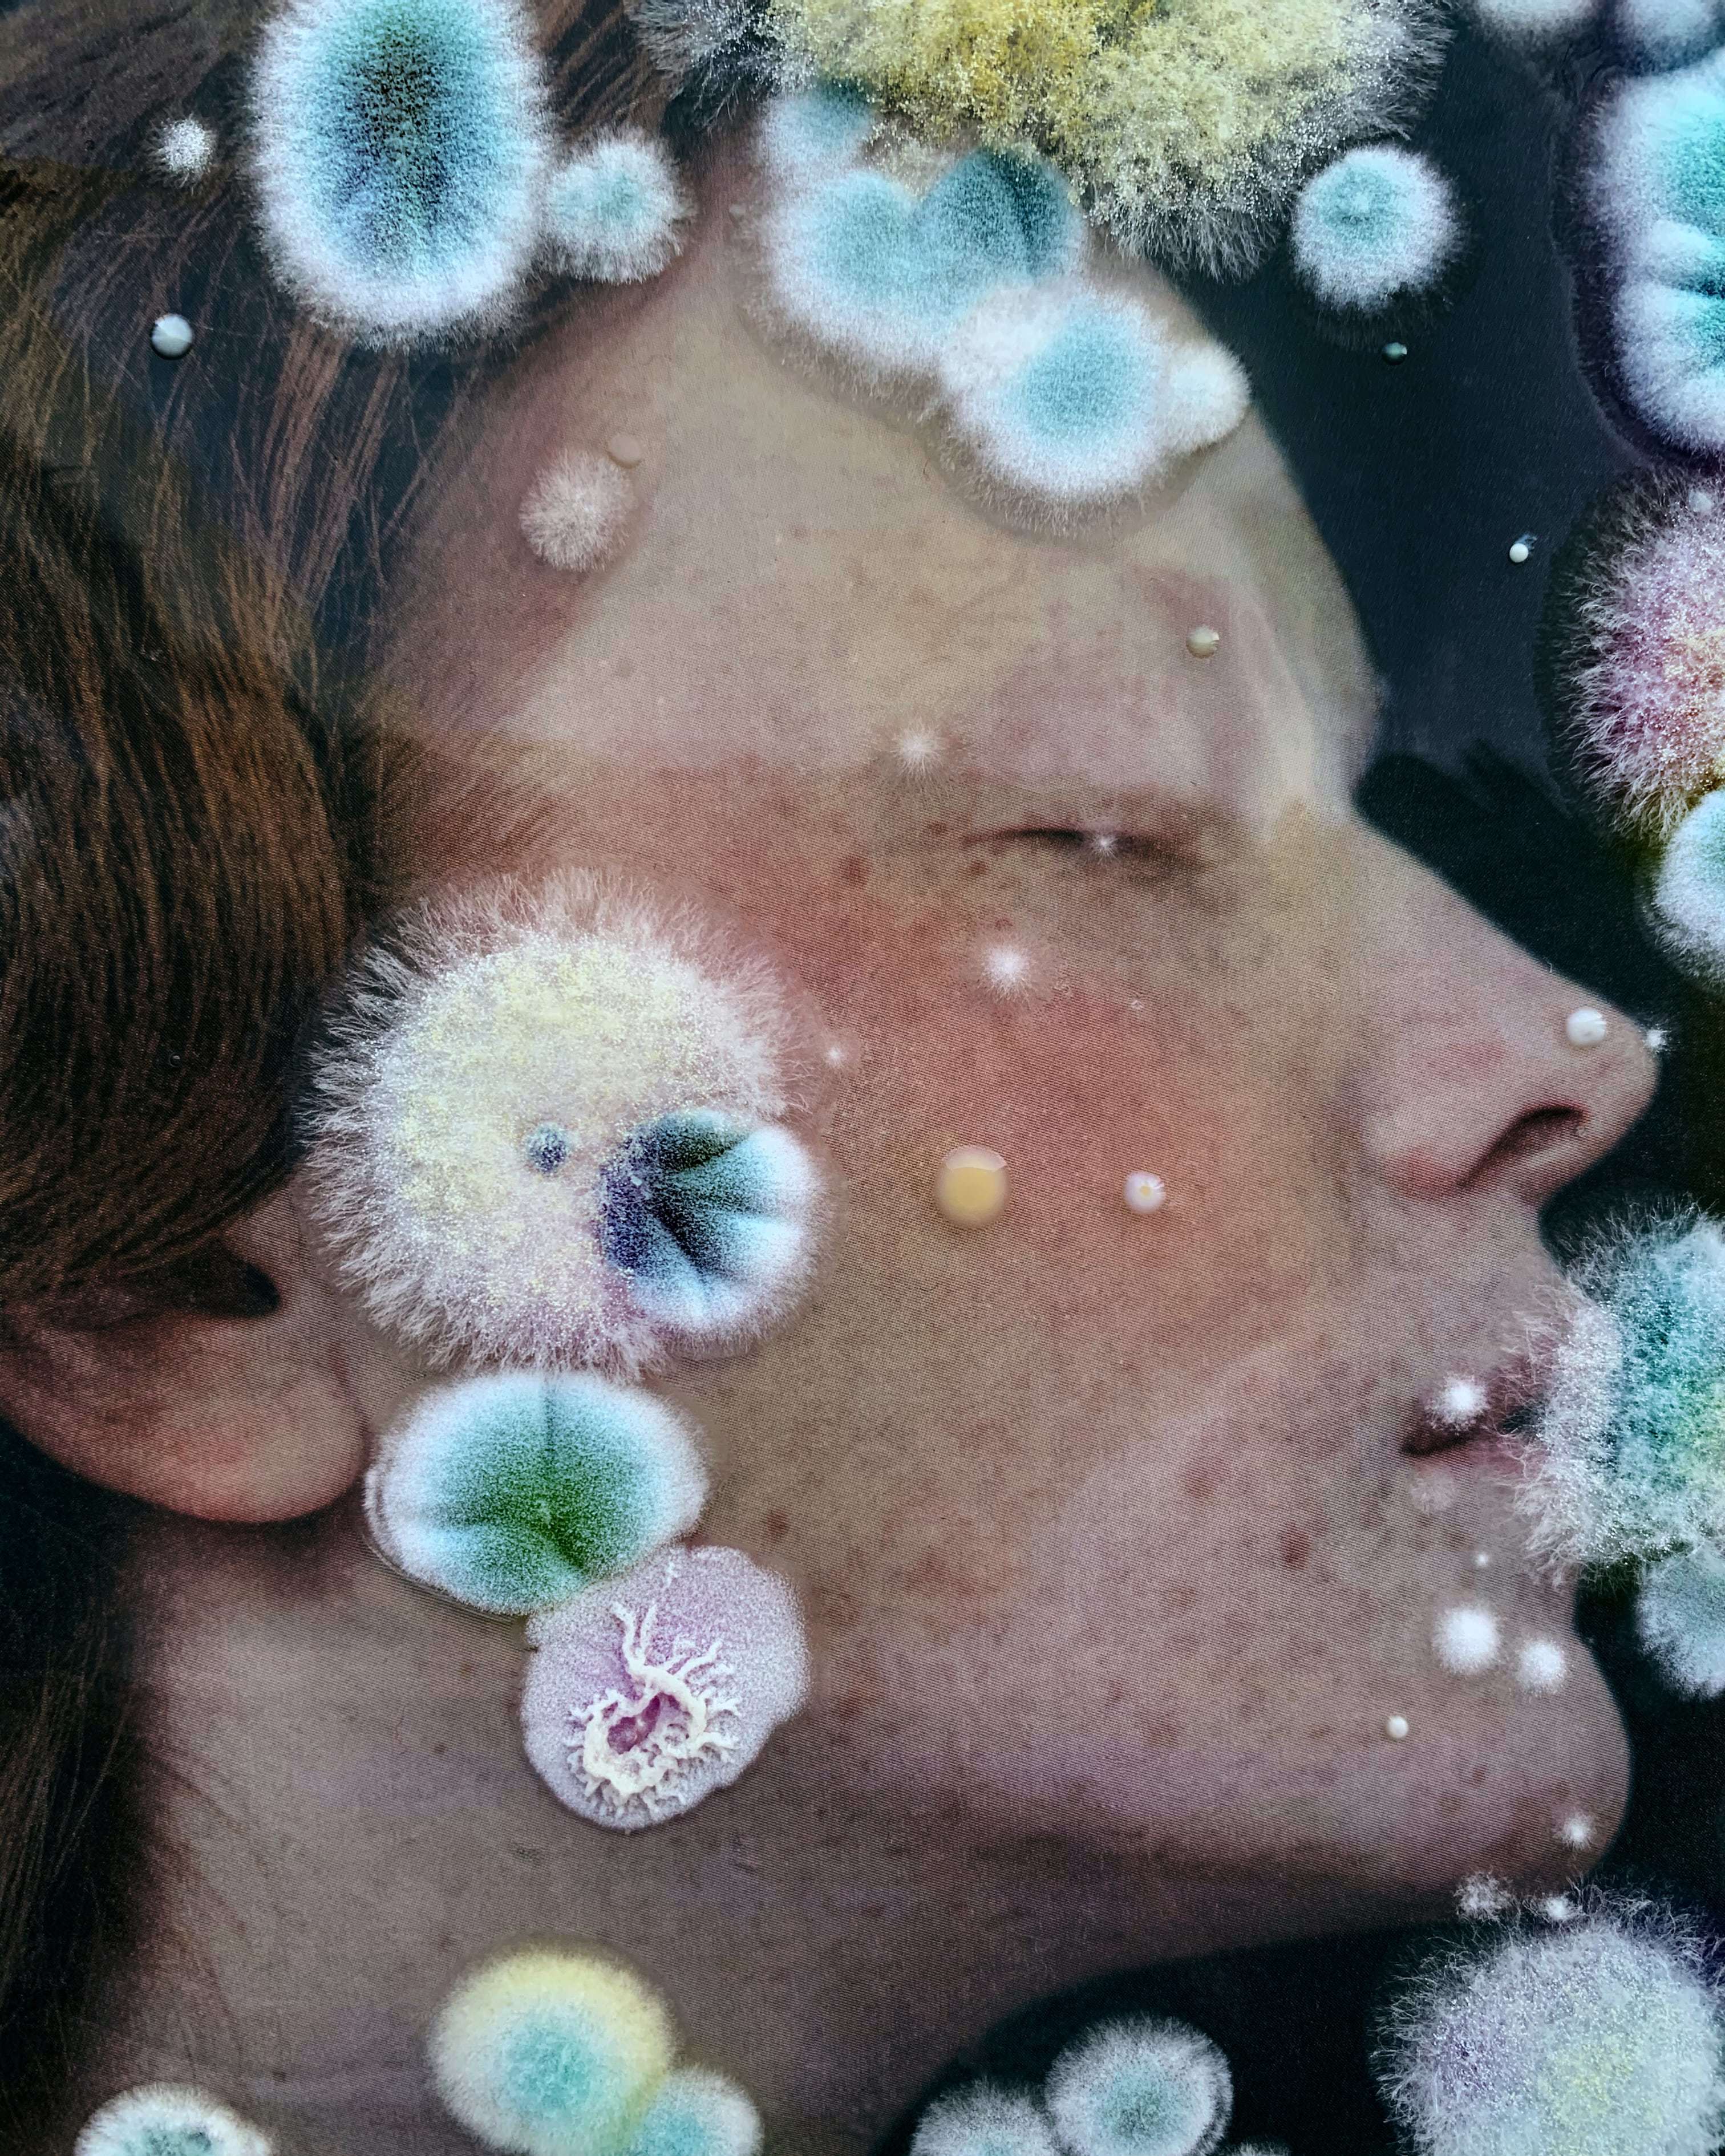
полезная плесень миф или правда. 7eb7b44d6b214af7e00c66d3c3bedb38. полезная плесень миф или правда фото. полезная плесень миф или правда-7eb7b44d6b214af7e00c66d3c3bedb38. картинка полезная плесень миф или правда. картинка 7eb7b44d6b214af7e00c66d3c3bedb38. полезная плесень миф или правда. 7eb7b44d6b214af7e00c66d3c3bedb38. полезная плесень миф или правда фото. полезная плесень миф или правда-7eb7b44d6b214af7e00c66d3c3bedb38. картинка полезная плесень миф или правда. картинка 7eb7b44d6b214af7e00c66d3c3bedb38.
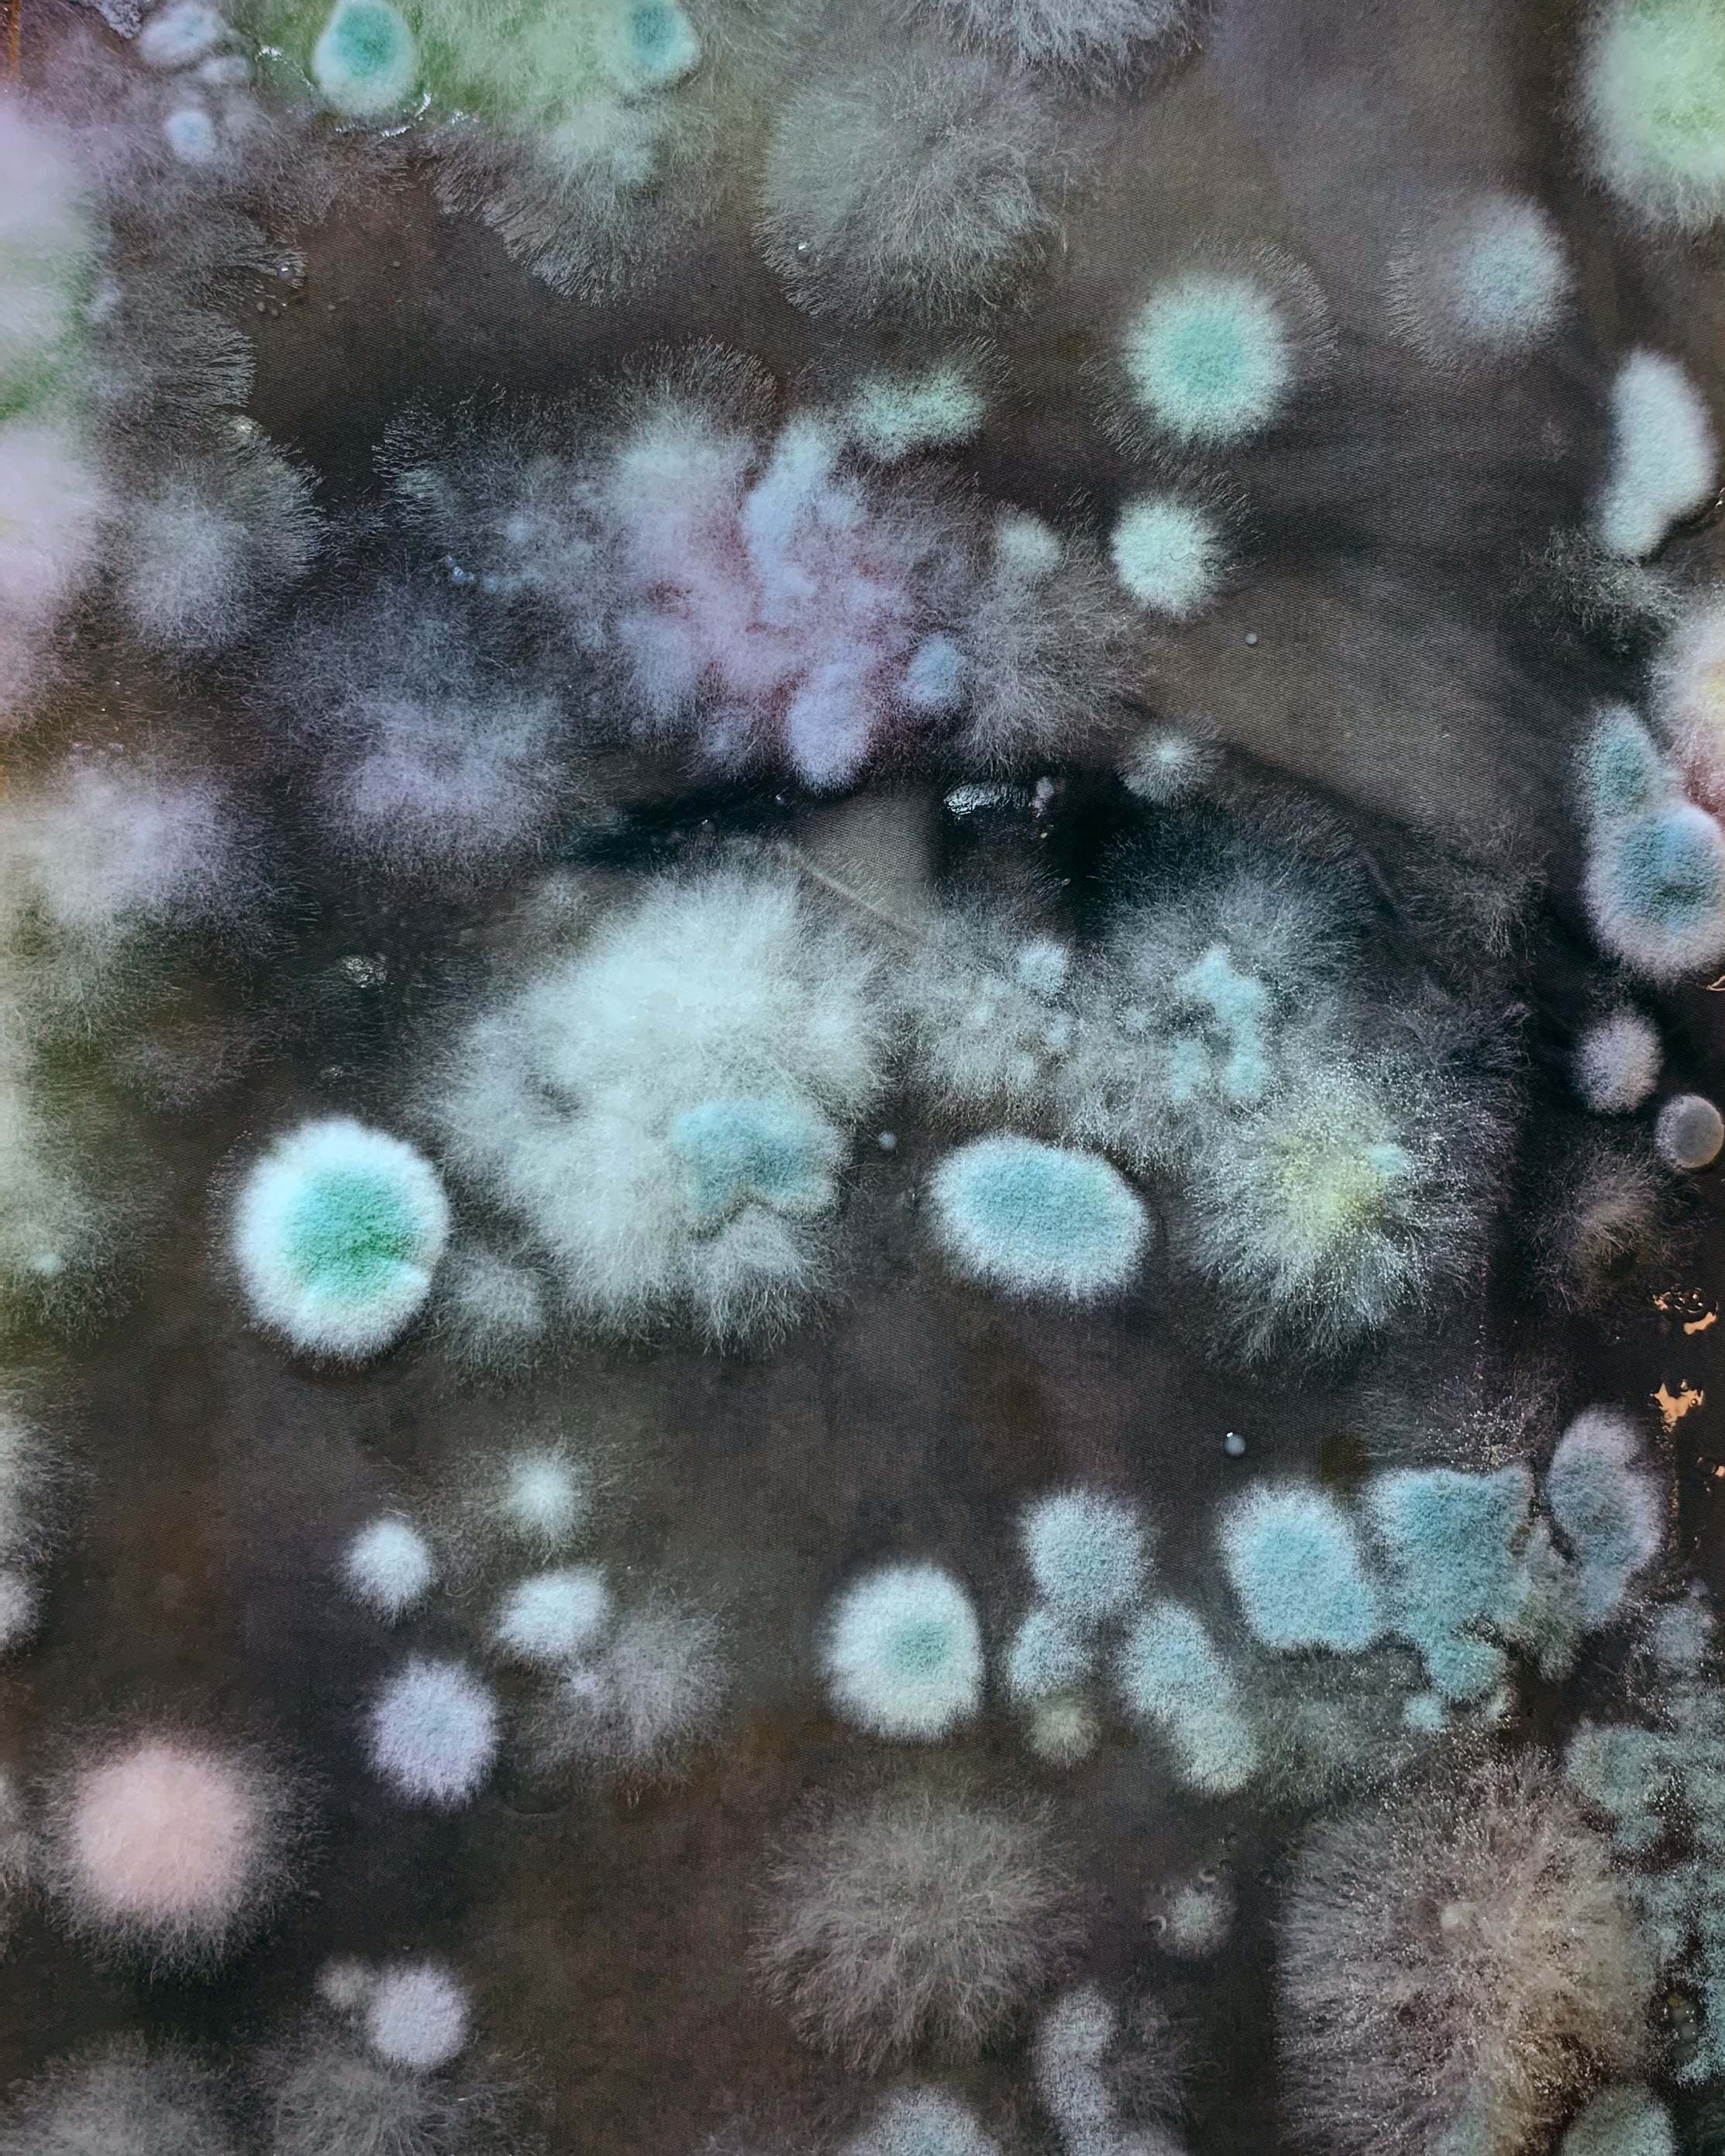
полезная плесень миф или правда. 5e438fd4e81cdf8015e6aaa7a3a9c764. полезная плесень миф или правда фото. полезная плесень миф или правда-5e438fd4e81cdf8015e6aaa7a3a9c764. картинка полезная плесень миф или правда. картинка 5e438fd4e81cdf8015e6aaa7a3a9c764. полезная плесень миф или правда. 5e438fd4e81cdf8015e6aaa7a3a9c764. полезная плесень миф или правда фото. полезная плесень миф или правда-5e438fd4e81cdf8015e6aaa7a3a9c764. картинка полезная плесень миф или правда. картинка 5e438fd4e81cdf8015e6aaa7a3a9c764.

полезная плесень миф или правда
Полезная плесень миф или правда
Проще говоря, дрожжи участвуют в изготовлении многих продуктов, без которых жизнь была бы менее веселой и вкусной. «Бояться употреблять продукты, содержащие дрожжи, точно не стоит. Дрожжи живут повсюду — на поверхности фруктов, овощей, растений и даже в воздухе, — рассказывает врач-гастроэнтеролог и терапевт клиники „Семейная“ Мария Бойко. — Более того, они живут на нас самих и составляют важную часть нашей собственной микрофлоры. Правда, у очень маленького процента людей бывает непереносимость дрожжевого белка или аллергия — вот им стоит избегать продуктов, содержащих большое количество дрожжей, остальные могут расслабиться». Выяснить, относитесь ли вы к этому проценту, поможет анализ на выявление непереносимости дрожжей — такие делают в большинстве лабораторий.
Кроме того, по словам Марии, дрожжи имеют высокую энергетическую ценность за счет большого содержания белка, а также могут похвастать большим количеством витаминов группы В. «Но намеренно добавлять в рацион большое количество дрожжей не стоит — большинство людей и так потребляет слишком много калорий», — добавляет гастроэнтеролог.
В косметологии тоже нашлось место дрожжевым грибам — их экстракт помогает предотвратить обезвоживание кожи, укрепляет ее защитный барьер, а еще из дрожжей выделяют бета-глюкан, который используется в качестве антиоксиданта.
Это не так, ведь хлеб проходит тепловую обработку, от которой дрожжи погибают. Это происходит уже примерно при 50 градусах, а хлеб пекут при гораздо более высокой температуре, так что живых дрожжей в выпечке не может быть по определению.
Именно это свойство используется при изготовлении пищевых дрожжей — по-английски они называются nutritional yeast и продаются в виде порошка или хлопьев желтого цвета. Из-за термической обработки при 45–50 градусах дрожжи инактивируются, но не разрушаются — белок и витамины в них сохраняются. За эту питательность такие дрожжи нередко записывают в разряд суперфудов, а за орехово-сырный вкус они популярны у веганов и у тех, кто по каким-то причинам не ест молочные продукты — с помощью пищевых дрожжей можно готовить многие блюда, в базовом рецепте которых должен использоваться сыр.
Представление о том, что в выпечке хлеба на закваске не используются дрожжи, ошибочно. Закваска — не что иное, как выращенные самостоятельно дрожжи вперемешку с молочнокислыми бактериями. Как уже говорилось выше, дрожжи живут практически на всем — на зерновых и муке в том числе. При приготовлении закваски в определенной пропорции смешивают небольшое количество муки с водой и оставляют киснуть в тепле в течение нескольких дней, периодически «подкармливая». Если все сделать правильно, в итоге получится продукт, обогащенный молочнокислыми бактериями и так называемыми дикими дрожжами. В хлебе на закваске нет готовых хлебопекарных дрожжей, но бездрожжевым его назвать никак нельзя, хотя некоторые специалисты его действительно считают более полезным из-за тех самых бактерий. Но тем, кто по каким-то причинам избегает дрожжей в питании, выпечка на закваске вряд ли может заменить обычную.
Начнем с того, что благодаря плесени человечество имеет в своем распоряжении пенициллин — антибиотик, с помощью которого удалось начать успешно лечить огромное количество серьезных заболеваний, включая некоторые пневмонии, менингиты, дифтерию, скарлатину, сибирскую язву и сифилис. Выделил пенициллин Александр Флемминг в 1928 году из штамма плесневого гриба пеницилла золотистого. С тех пор из плесени научились выделять и другие антибиотики — например, циклоспорин, стрептомицин и цефалоспорины.
Есть, разумеется, и обратная сторона у нашего симбиоза с плесенью. Некоторые ее виды выделяют смертельно опасные токсины — например, канцерогенные афлатоксины и Т-2 (в использовании последнего как химоружия в 80-е обвиняли Вьетнам и СССР, впрочем, без доказательств).
Поселяясь на субстрате, которым может быть не только пищевой продукт, но и бумага, дерево, ткань, плесень постепенно разрушает их, так что и те виды плесневых грибов, которые в целом безопасны для здоровья, могут доставлять неудобства и приводить к разного рода сложностям — например, уничтожать архивы и библиотеки.
В общем, панически бояться плесени не стоит, но и беспечности она вам не простит.
Важным фактором, который определяет, насколько плесень безопасна, является то, какие токсины — они называются микотоксинами — она выделяет. Иногда это может зависеть от того, чем плесневый гриб питается и в какой среде произрастает. При изготовлении некоторых сыров используют так называемые благородные виды плесневых грибов — например, в знаменитые сыры стилтон, горгонзола и рокфор идет голубая плесень, которая называется пеницилл рокфоровый, или P. roqueforti. В этих сырах она безопасна и отвечает за характерные вкус и запах, за которые мы эти продукты любим, но стоит ей перебраться на выпечку или зерно, то есть сменить среду обитания, она уже становится токсичной, может вызывать проблемы с пищеварением или аллергическую реакцию. Поэтому же и хранить такие сыры нередко предлагают в отсеке для овощей, где наиболее подходящие для хорошего поведения плесени влажность и температура.
Плесень, которая используется в пищевой промышленности намеренно — то есть контролируемо и при правильных условиях, — может значительно отличаться от той, что спонтанно выросла у вас в холодильнике на забытом кусочке колбаски. Если вы не склонны играть каждый день в русскую рулетку, лучше заплесневевший продукт отправить в мусорное ведро, ведь что за плесень вы вырастили и насколько глубоко ее грибница проникла в продукт, вы вряд ли сможете определить самостоятельно.
«Совершенно точно не стоит есть заплесневевшие мясные изделия, хлеб и выпечку, а также мягкие молочные продукты вроде творога и сметаны, в которые мицелий плесени проникает глубоко достаточно быстро, — поясняет микробиолог Валерий Михайлов. — А вот если на большом куске твердого сыра или на овоще появилось небольшое пятнышко, спасти их еще можно. Просто отрежьте часть с плесенью, захватив несколько свободных от плесени сантиметров продукта, чтобы точно избавиться от мицелия грибов». Впрочем, лучше таких ситуаций избегать, ведь микроскопические споры плесени могут поселиться и в самом холодильнике. По словам Михайлова, если вы заметили, что закупленные продукты поражаются плесенью с завидным постоянством, стоит взять за привычку регулярное мытье холодильника с противогрибковым очищающим средством. «Стопроцентной гарантии, что плесень больше не появится, это, конечно, не даст — споры плесневых грибов есть и в воздухе, мы постоянно живем бок о бок. Но все же вероятность заражения ими продуктов вы снизите», — добавляет микробиолог.
Мифы о плесени и их разоблачение
Наш долгий опыт общения с людьми, столкнувшимися с проблемой плесневого заражения помещений, показывает, что в среди населения бытует множество мифов о плесени, не имеющих ничего общего с реальностью. Ниже вы найдете перечисление наиболее распространенных мифов (в левой колонке) и их разоблачение (справа).
МИФЫ О ПЛЕСЕНИ
ПРАВДА О ПЛЕСЕНИ
«Плесень не опасна для здоровья, это чисто косметический дефект»
«Плесень вызывает рак» «Опасна только «черная плесень»
В помещениях, подвергшихся протечкам или затоплению, могут развиваться многие виды плесневых грибов, разные по своим свойствам. Среди них есть виды, более или менее вредные для здоровья человека, но все они достаточно вредны для того, чтобы немедленно забить тревогу при их появлении в квартире. Проживать в зараженных помещениях нельзя, особенно детям, пожилым людям и лицам с тяжелыми заболеваниями.
«В воздухе не должно быть ни одной споры плесени»
«Нужно часто включать в квартире ультрафиолетовую лампу и тогда плесени не вырастет»
Изначальным источником спор плесневых грибов является окружающая природная воздушная среда, в которой они в норме присутствуют в незначительных фоновых количествах. Полностью избавиться от присутствия спор плесневых грибов в окружающей нас среде невозможно, да и не нужно. Однако следует учитывать, что при наличии благоприятных условий (повышенная влажность) немногочисленные споры плесневых грибов начинают массово размножаться, субстратом для них служит широкий круг материалов, в том числе строительные и отделочные материалы, ткани, древесина, некоторые полимеры и т. д.
Использование ультрафиолетовых ламп достаточно опасно для здоровья человека, т.к. приводит к образованию свободных радикалов в воздухе. Применение УФ-облучателей резонно для медицинских учреждений, но никак не для постоянного применения в квартирах. Как уже говорилось выше, пытаться избавиться от единичных спор плесени бессмысленно (они появятся после первого же проветривания, которое, кстати, необходимо делать после УФ-облучения). К тому же УФ-облучение более эффективно против бактерий и вирусов, тогда как многие споры грибов обладают толстыми клеточными стенками, надежно защищающими их от убивающего воздействия УФ-излучения. Гораздо правильнее поддерживать нормальный микроклимат в квартире и не допускать переувлажнения материалов и скопления конденсата на поверхностях.
«Плесень невозможно вывести, если она однажды появилась»
Вывести (уничтожить) плесень вполне можно, в этом явлении нет ничего сверхъестественного. Нужно лишь получить грамотные рекомендации специалистов-микологов по объемам удаления пораженных материалов и по антисептическим средствам, которыми нужно обработать пораженные поверхности, или воспользоваться услугами профессионалов по удалению плесени (с гарантией). Однако имейте в виду, что эффективны далеко не все антиплесневые средства, широко представленные в строительных магазинах. По нашему опыту, лишь 2-3 средства реально действуют, надежно удаляя плесень и защищая от ее повторного появления. Однако предупреждаем, что нет ни одного средства, которое бы защитило ваш дом от плесени навечно, невзирая на аварийные ситуации. Антисептики, даже самые лучшие, со временем разлагаются, также они вымываются водой при сильных протечках. Кроме того, для жилой среды запрещено использовать некоторые особенно сильные препараты, так как они токсичны.
«Если хорошо замуровать плесень под отделочными материалами, она не принесет вреда и не вылезет»
«Плесень не может появиться за неделю»
«Если нет запаха плесени, то и самой плесени тоже нет»
Это абсолютно неверное мнение, культивируемое некоторыми представителями жилищно-эксплуатационных служб для усыпления бдительности жильцов, пострадавших от аварий, связанных с заливом помещений. Не всегда развитие плесени сопровождается появлением характерного запаха (это зависит от видов плесневых грибов, от степени и длительности поражения).
«После обработки антисептиком остатки плесени неопасны и их можно не удалять»
Это абсолютно неверное мнение, т. к. споры плесневых грибов сохраняют аллергенные и токсигенные свойства даже после обработки антисептиками. Аллергенность грибов никак не связана с их жизнеспособностью, а связана с белковыми компонентами, которые входят в состав клеточной стенки грибов. Поэтому обычно требуется полное удаление пораженных плесенью строительных и отделочных материалов (гипсокартон, обои, краска, шпаклевка, штукатурный слой в очагах поражения).
«Если квартиру залили год назад, появившаяся неделю назад плесень связана с этим заливом»
Если после залива квартира была быстро просушена, и в течение 2-3 месяцев нет никаких признаков заражения плесенью, неожиданное ее появление скорее всего вызвано другими причинами. Как указано выше, плесень развивается быстро и только на влажных материалах.
«После протечки к нам переползла плесень от соседей!»
Если произошел сильный залив, затронувший соседние квартиры или квартиры на нескольких этажах, и во всех квартирах начала появляться плесень (возможно, не одновременно), то скорее всего она появляется в каждой квартире независимо, из своих, «внутренних» источников, под влиянием влажности из промокших стен, полов, потолков. Конечно, если рядом с вашей квартирой длительное время (месяцы или годы) находится сильно зараженное жилье, нельзя исключить вероятность прорастания плесени от них к вам. Однако при случайных авариях пенять на соседей неправильно. Споры плесени всегда есть вокруг нас, и попав на влажные материалы они прорастут и будут развиваться.
Мы всегда готовы проконсультировать Вас по бесплатной линии 8(800) 550-25-09
Мифы о плесени, правдивые и не очень
Наш долгий опыт работы с плесенью показывает, что среди людей столкнувшихся с этой проблемой бытует множество мифов о плесени. Некоторые из них, самые популярные, мы в данной статье разоблачим.
Популярные заблуждения и мифы о плесени и их опровержения
МИФ №1. Плесень-это только косметический дефект
Плесень вредна для здоровья при вдыхании, при контакте с кожей. Может вызывать как аллергические заболевания(весь спектр бронхиты, риниты, дерматиты, астма…), так и глубокие микозы ( поражение плесневыми грибами внутренних органов ).
МИФ №2. Плесень вызывает рак
Нет научных доказательств, что контакт с плесневыми грибами как — либо связан с возникновением раковых заболеваний. Связь между этими факторами возможна лишь очень опосредованным способом – через влияние на иммунную систему.
МИФ №3. Все, что может вызвать плесень — это насморк
Гиперчувствительность к плесневым грибам(т.н. микогенную сенсибилизацию) можно в некоторых случаях выявить путем серологических тестов сделать анализ крови на присутствие антител к аллергенам плесени. Тем не менее, у некоторых людей, несмотря на годы жизни в зараженном помещении, такой сенсибилизации не возникает.
МИФ №4. Опасна только «черная плесень«
В помещениях, подвергшихся протечкам или затоплению, могут развиваться многие виды плесневых грибов, разные по своим свойствам. Среди них есть виды, более или менее вредные для здоровья человека, но все они достаточно вредны для того, чтобы немедленно забить тревогу при их появлении в квартире.
Проживать в зараженных помещениях нельзя, особенно детям, пожилым людям и лицам с тяжелыми заболеваниями.
МИФ №5. В воздухе не должно быть спор плесени вообще
Изначальным источником спор плесневых грибов является окружающая природная воздушная среда, в которой они в норме присутствуют в незначительных фоновых количествах. Полностью избавиться от плесени в окружающей нас среде невозможно, да и не нужно.
Однако следует учитывать, что при наличии благоприятных условий (повышенная влажность) немногочисленные споры плесневых грибов начинают массово размножаться, субстратом для них служит широкий круг материалов, в том числе строительные и отделочные материалы, ткани, древесина, некоторые полимеры и т.д.
МИФ №6. Нужно использовать ультрафиолетовую лампу от плесени
Использование ультрафиолетовых ламп достаточно опасно для здоровья человека, т.к. приводит к образованию свободных радикалов в воздухе. Применение УФ-облучателей резонно для медицинских учреждений, но никак не для постоянного применения в квартирах. Как уже говорилось выше, пытаться избавиться от единичных спор плесени бессмысленно (они появятся после первого же проветривания, которое, кстати, необходимо делать после УФ- облучения).
К тому же УФ — облучение более эффективно против бактерий и вирусов, тогда как многие споры грибов обладают толстыми клеточными стенками, надежно защищающими их от убивающего воздействия УФ-излучения. Гораздо правильнее поддерживать нормальный микроклимата квартире и не допускать переувлажнения материалов и скопления конденсата на поверхностях
МИФ №7. Невозможно избавиться от плесени, если она однажды появилась
Кроме того, для жилой среды запрещено использовать некоторые особенно сильные препараты, так как они токсичны. Самый лучший способ удаления плесени это СВЧ-метод. Безопасно и гарантированно лечит даже самые сложные ситуации. Подробнее об этом вы можете прочитать в специальном разделе нашего сайта
МИФ №8. Если заделать плесень отделочными материалами — то она не причинит вреда и не прорастет
Это абсолютно неверное мнение, так как в силу микроскопического размера споры плесневых грибов легко проникают через мельчайшие зазоры, заражая воздух в квартире и создавая аллергенный микроклимат. Замуровать плесень полностью невозможно.
МИФ №9. Плесень не может появиться за пару дней
Использование современных отделочных материалов (гипсокартонные конструкции, пластик, винил и т. п.) значительно затрудняет быстрое высыхание помещений. Под напольными и настенными покрытиями из — за этого почти в 100% случаев в течение 1-3 недель после аварии развивается массовое плесневое поражение.
МИФ №10. Если нет запаха плесени, то плесени нет тоже
МИФ №11. После обработки антисептиками- необязательно удалять остатки плесени. Они-безопасны.
МИФ №12. Медный купорос — решение проблемы!
Медный купорос — даже не вчерашний, а позавчерашний день в антиплесневой обработке. Это токсичное соединение тяжелого металла – меди, в повышенных количествах опасное для здоровья человека (а именно в таких количествах его нужно применять для достижения антиплесневого эффекта). Есть современные эффективные и безопасные средства и методы для борьбы с плесенью.
МИФ №13. После протечки к нам переползла плесень от соседей
Если произошел сильный залив, затронувший соседние квартиры или квартиры на нескольких этажах, и во всех квартирах начала появляться плесень (возможно, не одновременно), то скорее всего она появляется в каждой квартире независимо, из своих, «внутренних» источников, под влиянием влажности из промокших стен, полов, потолков.
Конечно, если рядом с вашей квартирой длительное время (месяцы или годы) находится сильно зараженное жилье, нельзя исключить вероятность прорастания плесени от них к вам. Однако при случайных авариях пенять на соседей неправильно. Споры плесени всегда есть вокруг нас, и попав на влажные материалы они прорастут и будут развиваться
Надеемся мы разоблачили мифы о плесени
Полезная плесень миф или правда
Не всякая плесень – пенициллин!
Что это такое?
Плесень, или грибки – одни из древнейших микроорганизмов на нашей планете. Люди давно научились использовать микроорганизмы во благо. Их применяют при изготовлении соевого соуса и некоторых сортов сыра. Благодаря чудесным свойствам плесени был открыт знаменитый антибиотик пенициллин, спасший многие тысячи жизней. Однако, не всякая плесень полезна. Множество видов грибков способны вызывать различные кожные и системные заболевания, в том числе, аллергические. Плесень на продуктах питания может быть причиной тяжелого пищевого отравления. Грибки в процессе своей жизнедеятельности выделяют токсичные вещества, большая часть которых имеет стабильную химическую структуру и не разрушается при тепловой обработке пищи. Некоторые плесневые токсины обладают канцерогенным свойством. Поэтому следует лишний раз подумать, если отважитесь использовать заплесневелый продукт. Хотя большинство видов грибков предпочитают тепло, многие могут расти и при температурах холодильной камеры. Плесень лучше других микроорганизмов устойчива к соли, сахару и может расти в холодильнике на варенье, колбасе и других продуктах.
Есть или не есть?
Несмотря на повсеместное распространение плесневых грибков, их бурный рост и развитие требует особых условий. Влажность и рыхлая структура продукта играют при этом не последнюю роль. Заплесневелый хлеб следует сразу же утилизировать. Не имеет значения размер плесневой колонии, выросшей на поверхности хлеба. Из-за своих микроскопических размеров, плесень распространяет свои споры на весь батон, зеленые островки – лишь видимые участки разросшихся колоний. Плесень чаще встречается на хлебобулочных изделиях, а также на овощах, фруктах, зерне, орехах. При этом имеет большое значение не только производство, но и транспортировка и хранение пищевой продукции. При выборе продуктов на развес, обращайте внимание на их внешний вид. Любая пищевая продукция, подвергнутая заражению плесенью, не может быть использована в пищу! Она не должна находиться в обороте, на полках магазинов.
Если нашел плесень?
Все это не касается продуктов, присутствие плесени на которых является частью технологического процесса. Но в таком случае на этикетке продукта это указано («Сыр с плесенью» и плесень в составе). Отличить ту самую «благородную» плесень от ядовитой очень легко — по цвету и по фактуре.
Как предотвратить рост плесени?
Плесень на продуктах – опасна или нет?
Вы обнаружили на продукте плесень. Выбросить его или можно очистить и использовать в пищу? Разбираемся в статье.
Какой бывает плесень
Плесень, или грибки, – один из древнейших микроорганизмов на нашей планете. Люди давно научились использовать микроорганизмы во благо. Ее применяют при изготовлении соевого соуса и некоторых сортов сыра. Благодаря чудесным свойствам плесени был открыт знаменитый антибиотик пенициллин, спасший многие тысячи жизней.
Однако не всякая плесень полезна. Множество видов грибков способны вызывать различные кожные и системные заболевания, в том числе аллергические. Плесень на продуктах питания может быть причиной тяжелого пищевого отравления. Грибки в процессе своей жизнедеятельности выделяют токсичные вещества, большая часть которых имеет стабильную химическую структуру и не разрушается при тепловой обработке пищи. Некоторые плесневые токсины обладают канцерогенным свойством.
Поэтому следует лишний раз подумать, если отважитесь оставить заплесневелый продукт. Хотя большинство видов грибков предпочитают тепло, многие могут расти и при температурах холодильной камеры. Плесень лучше других микроорганизмов устойчива к соли и сахару и может расти в холодильнике на варенье, колбасе и других продуктах.
Несмотря на повсеместное распространение плесневых грибков, их бурный рост и развитие требует особых условий. Влажность и рыхлая структура продукта играют при этом не последнюю роль. Заплесневелый хлеб следует сразу же утилизировать. Не имеют значения размеры плесневой колонии, выросшей на поверхности хлеба. Из-за своих микроскопических размеров плесень распространяет свои споры на весь батон, зеленые островки – лишь видимые участки разросшихся колоний.
Плесень чаще встречается на хлебобулочных изделиях, а также на овощах, фруктах, зерне, орехах. При этом имеет большое значение не только производство, но и транспортировка и хранение пищевой продукции. При выборе продуктов на развес обращайте внимание на их внешний вид. Любая пищевая продукция, подвергнутая заражению плесени, не может быть использована в пищу. Она не должна находиться в обороте, на полках магазинов.
Что делать, если обнаружили плесень
Плесень на мясе, сосисках, йогурте, сметане, мягких сырах, мягких фруктах и овощах требует немедленной утилизации этих продуктов. То же относится к хлебобулочным изделиям, орехам и желе. Специалисты допускают использование некоторых продуктов с плотной и сухой структурой (например, сыры), если возможно аккуратно удалить плесень ножом. Обрежьте не менее 2,5 см вокруг зараженного участка. Не прикасайтесь ножом к плесени и оберните сыр в новую упаковку (пищевую пленку).
То же касается сыровяленой колбасы (салями). Небольшой слой белесого налета – нормальное явление. Твердые овощи типа моркови и капусты следует тщательно очистить, отрезав пораженные участки. Что же касается варенья – мнения расходятся. Дело в том, что нельзя гарантировать достаточной плотности для защиты более глубоких слоев от заражения.
Все это не касается продуктов, присутствие плесени на которых является частью технологического процесса. Но в таком случае на этикетке продукта это указано («Сыр с плесенью» и плесень в составе). Отличить ту самую «благородную» плесень от ядовитой очень легко – по цвету и фактуре.
Как предотвратить рост плесени
Не храните скоропортящиеся продукты в открытом виде в шкафу или холодильнике.
Хлеб храните отдельно.
Закрывайте банки крышками, а еду упаковывайте в целлофановые пакеты или пищевую пленку.
Регулярно меняйте кухонные губки и тряпки.
Хотя бы раз в месяц мойте холодильник и кухонные шкафы слабым раствором соды (2–3 чайные ложки пищевой соды на литр воды).
Правильно стерилизуйте банки с домашними консервами.